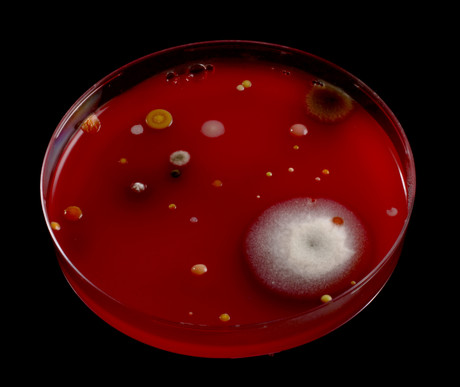
Penicillin allergy linked to greater risk of superbug infections

Penicillin allergy linked to greater risk of superbug infections
Patients who have a penicillin allergy recorded in their medical records are at an increased risk of developing the drug-resistant ‘superbug’ infection MRSA and healthcare-associated infection C. difficile, according to a new study published in The BMJ.
The risk is largely due to the use of more ‘broad spectrum’ antibiotics as alternatives to penicillin, which may be fuelling the development of drug-resistant bacteria.
Penicillin allergy is the most commonly documented drug allergy, reported by about 10% of patients; however, previous studies have shown that more than 90% of patients with listed penicillin allergies can be safely treated with penicillins. To evaluate the public health consequences of a penicillin allergy label, researchers at Massachusetts General Hospital examined the relation between penicillin allergy and development of MRSA and C. difficile.
Using data from The Health Improvement Network (THIN), an electronic medical record database of 11 million UK patients, they identified 64,141 adults with a documented penicillin allergy and 237,258 matched adults of similar age and sex, with recent penicillin exposure but without a penicillin allergy. None of the participants had any history of MRSA and C. difficile infection and were followed up for an average of six years, during which time use of antibiotics and cases of doctor diagnosed MRSA and C. difficile were recorded.
A total of 1345 participants developed MRSA and 1688 developed C. difficile over the follow-up period. After adjusting for several known risk factors, the researchers found that a penicillin allergy label was associated with a 69% increased risk of MRSA and a 26% increased risk of C. difficile.
Once documented, a penicillin allergy was associated with increased use of broad spectrum antibiotics, which act against a wider range of bacteria. The results show that increased use of broad spectrum antibiotics accounted for more than half (55%) of the increased MRSA risk and more than one-third (35%) of the increased C. difficile risk among patients with a listed penicillin allergy.
The researchers noted that theirs was an observational study, so no firm conclusions can be drawn about cause and effect. However, they point out that this was a large, representative sample and the findings remained consistent after further analyses to test the strength of the results.
As such, they wrote that patients with a documented penicillin allergy “have an increased risk of new MRSA and C difficile that may be modifiable, to some degree, through changes in antibiotic prescribing”.
“As infections with resistant organisms increase, systematic efforts to confirm or rule out the presence of true penicillin allergy may be an important public health strategy to reduce the incidence of MRSA and C difficile,” they added.
AusBiotech partners with Tenmile
Designed to support Australia's homegrown life sciences innovation, AusBiotech has announced...
Australian CDC issues update in wake of Ebola outbreak
After the WHO determined the outbreak of Ebola in the DRC and Uganda to be a public health...
Australia announces $7.2m diphtheria outbreak response package
To respond to the biggest diphtheria outbreak on record, support has been announced for the NT...



